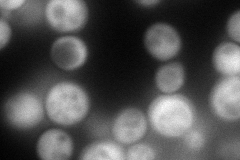
YOR339C
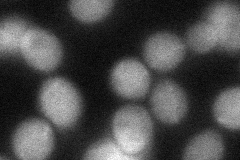
YOR339C

View description
Ubiquitin-conjugating enzyme most similar in sequence to Xenopus ubiquitin-conjugating enzyme E2-C, but not a true functional homolog of this E2; unlike E2-C, not required for the degradation of mitotic cyclin Clb2
Localization:
Intensity:
Fold change:
Significance:
-
C’ GFP library in SD

below threshold19.3 -
N' NOP1pr-GFP in SD
cytosol169.237 -
N' TEF2pr-mCherry in SD

cytosol204.675 -
N' NATIVEpr-GFP in SD

below threshold20.4851 -
N' TEF2pr-VC and Cyto-VN in SD
cytosol46.6267 -
C’ GFP library in SD+DTT

cytosol18.270.94No -
C’ GFP library in SD+H2O2

cytosol16.220.83No -
C’ GFP library in Starvation Media

cytosol16.790.86No -
C’ GFP library on the background of Pup2-DaMP

below threshold -
C’ GFP library on the background of CCT mutant

below threshold16.72050.865604No
